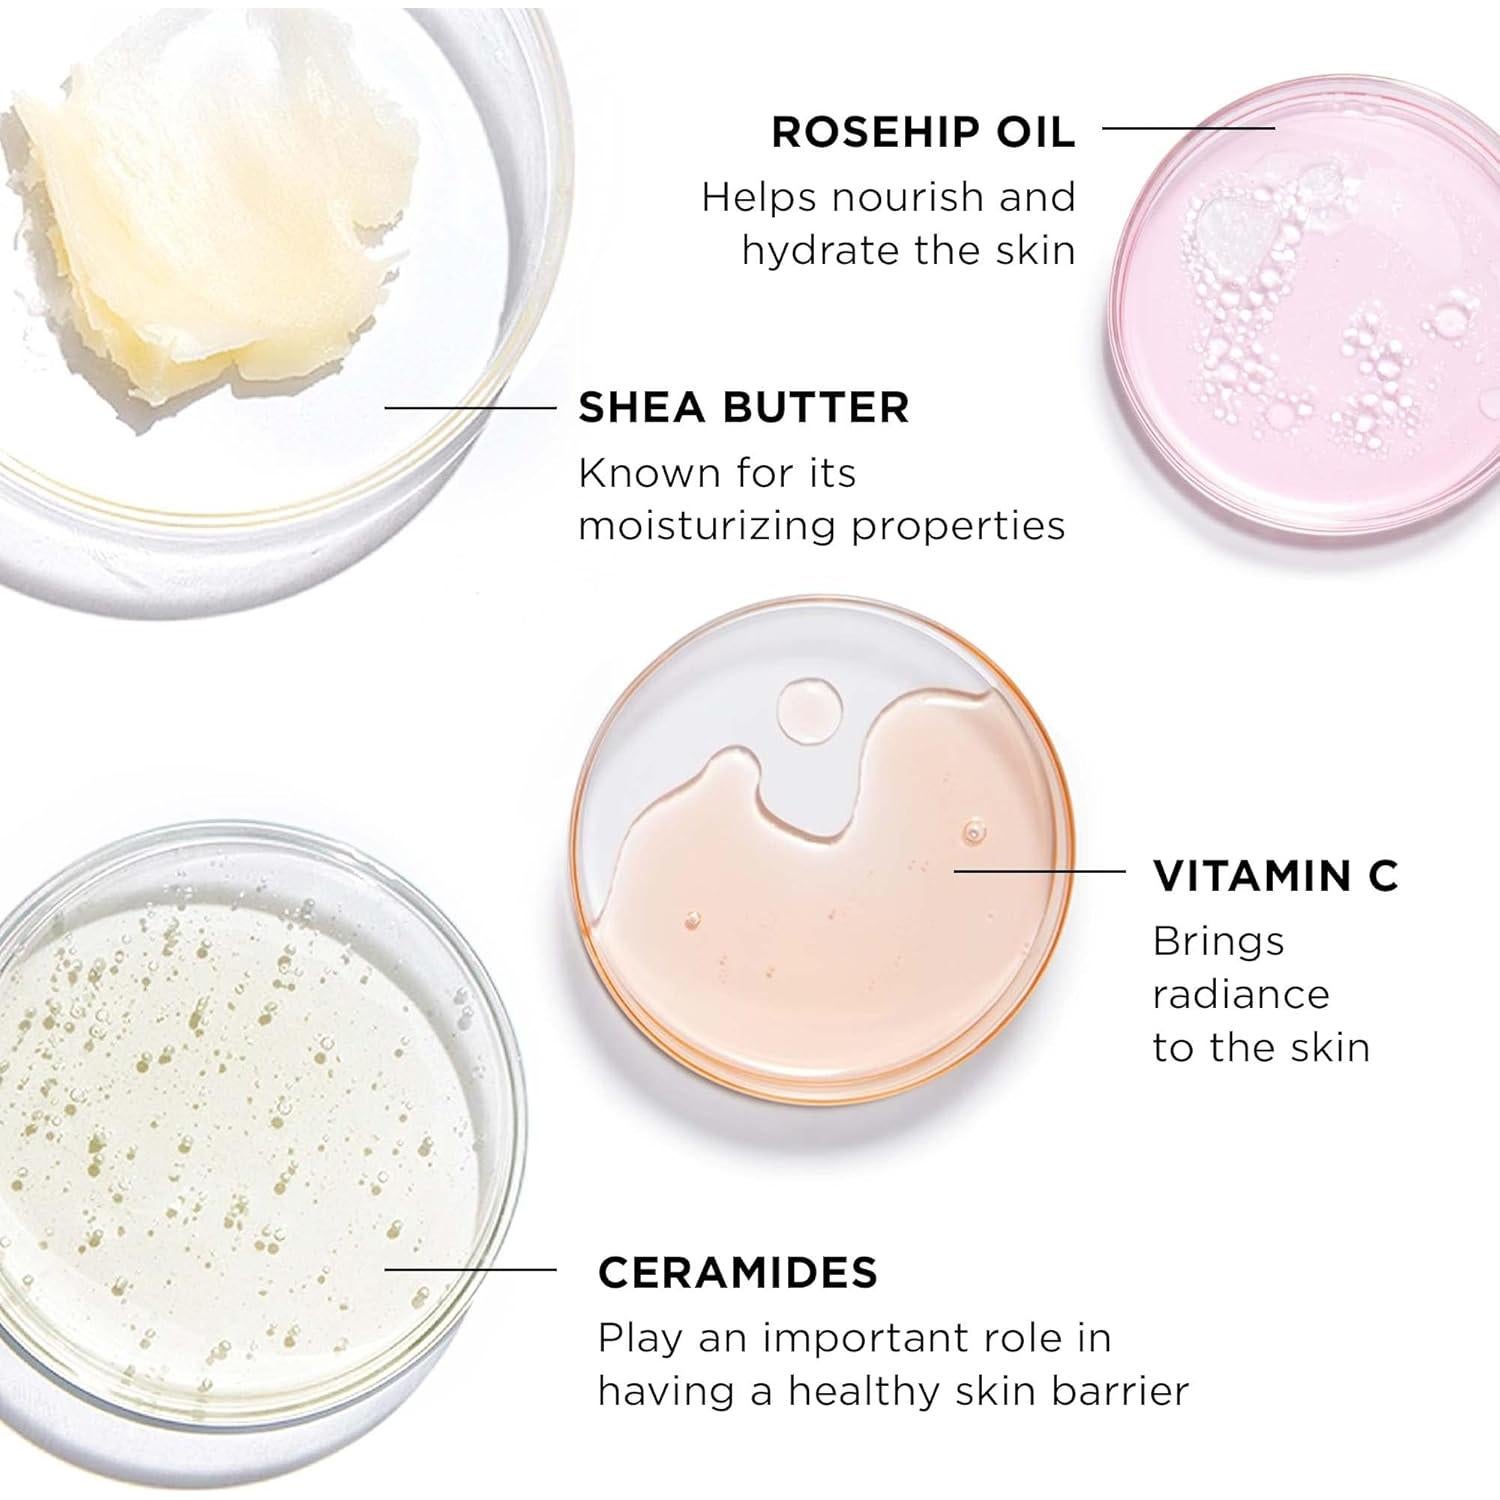
Bálsamo Limpiador 3 en 1 IT Cosmetics Bye Bye Makeup 113 g

Neutrogena
Bálsamo Limpiador 3 en 1 IT Cosmetics Bye Bye Makeup 113 g

300+ vendidos
Bálsamo Limpiador 3 en 1 IT Cosmetics Bye Bye Makeup 113 g
$56.528
40% OFF+ impuestos: $11.871
Llega a domicilio entre el 6 y el 11 de feb
- Compra protegida
- Envío a todo el país
- Garantía de entrega
Características destacadas
Opiniones de compradores
257 opiniones
Las opiniones provienen de compradores verificados en Amazon.
Descripción
Especificaciones técnicas
- Fabricante
- IT Cosmetics
- Dimensiones del producto
- 9.24 x 9.24 x 4.95 cm; 113.4 g
- Número de modelo del artículo
- S5038600
Preguntas y respuestas
Tu pregunta fue enviada. Te responderemos pronto.
¿Dónde te enviamos la respuesta?
Tus preguntas
· Recibirás la respuesta a
Productos relacionados
Neutrogena
Toallitas Desmaquillantes Neutrogena 20 Unidades Individuales
Garnier
Agua Micelar Garnier 400ml, Limpiador Facial Vegano, 2 Unidades
Garnier






